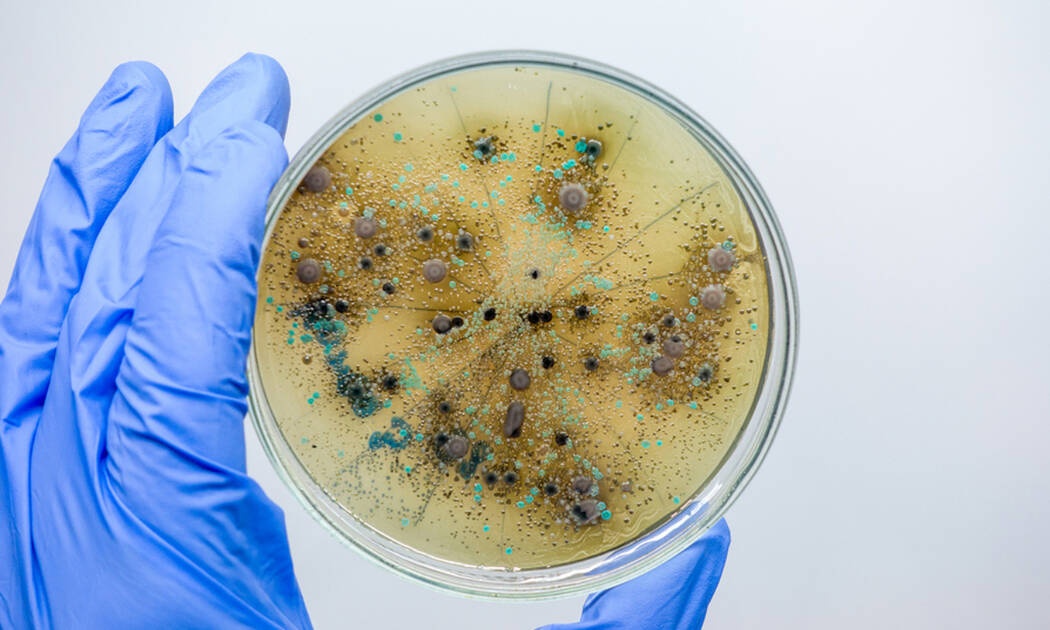
4 βρώμικα αντικείμενα καθημερινής χρήσης (εικόνες)

4 βρώμικα αντικείμενα καθημερινής χρήσης (εικόνες)
Μπορεί να μην το φαντάζεστε, αλλά πολλά από τα προσωπικά σας αντικείμενα είναι εστίες μικροβίων και πρέπει να τα αλλάζετε ανά τακτά διαστήματα.
Δεν πάει το μυαλό σας...
Διαβάστε περισσότερα στο Onmed.gr
ΡΟΗ ΕΙΔΗΣΕΩΝ



























